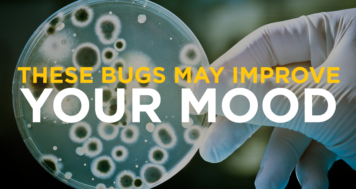
These Bugs May Improve Your Mood

Debilitating brain disorders are on the rise–from children being diagnosed with autism and ADHD to adults developing dementia at younger ages than ever before. But a medical revolution is underway. Astonishing research reveals that the health of your brain is, to an extraordinary degree, dictated by the state of your microbiome–the vast population of organisms that live in your body and outnumber your own cells ten to one. What’s taking place in your intestines today is determining your risk for any number of brain-related conditions.
In Brain Maker, Dr. Perlmutter explains the potent interplay between intestinal microbes and the brain, describing how the microbiome develops from birth and evolves based on lifestyle choices, how it can become “sick,” and how nurturing gut health can alter your brain’s destiny for the better. With dietary recommendations and a program of six steps to improve gut ecology, Brain Maker opens the door to unprecedented brain health potential. Brain Maker has been translated in over ten languages, including Spanish, Danish, German, Japanese, Mandarin, and Portuguese!
Click here to watch the videos and testimonials referenced in Brain Maker.
David Perlmutter is a leader in this burgeoning field, and his new book is a landmark contribution.
DALE BREDESEN, MD
PROFESSOR, UCLA
Related Blog Posts

Gut Bacteria and Their Role in Depression

The Microbiome – Implications for Global Health

Exercising to Improve Gut Health

Autism and Gut Bacteria – Hope Moving Forward

Why Supplementing with Prebiotic Fiber Makes Sense

Reversing Alzheimer’s with Probiotics?

Healthy Gut Bacteria – Diversity is the Key

How Long Does it Take to Improve Gut Bacteria?
These Bugs May Improve Your Mood

Gut Inflammation Affects the Brain

Psoriasis – A Gut Related Disorder

If I Don’t Gain Weight Is It OK To Eat Sugar?

Probiotic Intervention Affects Mood

Research – Probiotic Intervention Affects Mood

How Gut Bacteria Protect The Brain
Paradigm-shifting. By connecting the dots from our gut to our brain, Dr. Perlmutter gives us a fighting chance against brain decline.
JOHN RATEY, MD
HARVARD MEDICAL SCHOOL











